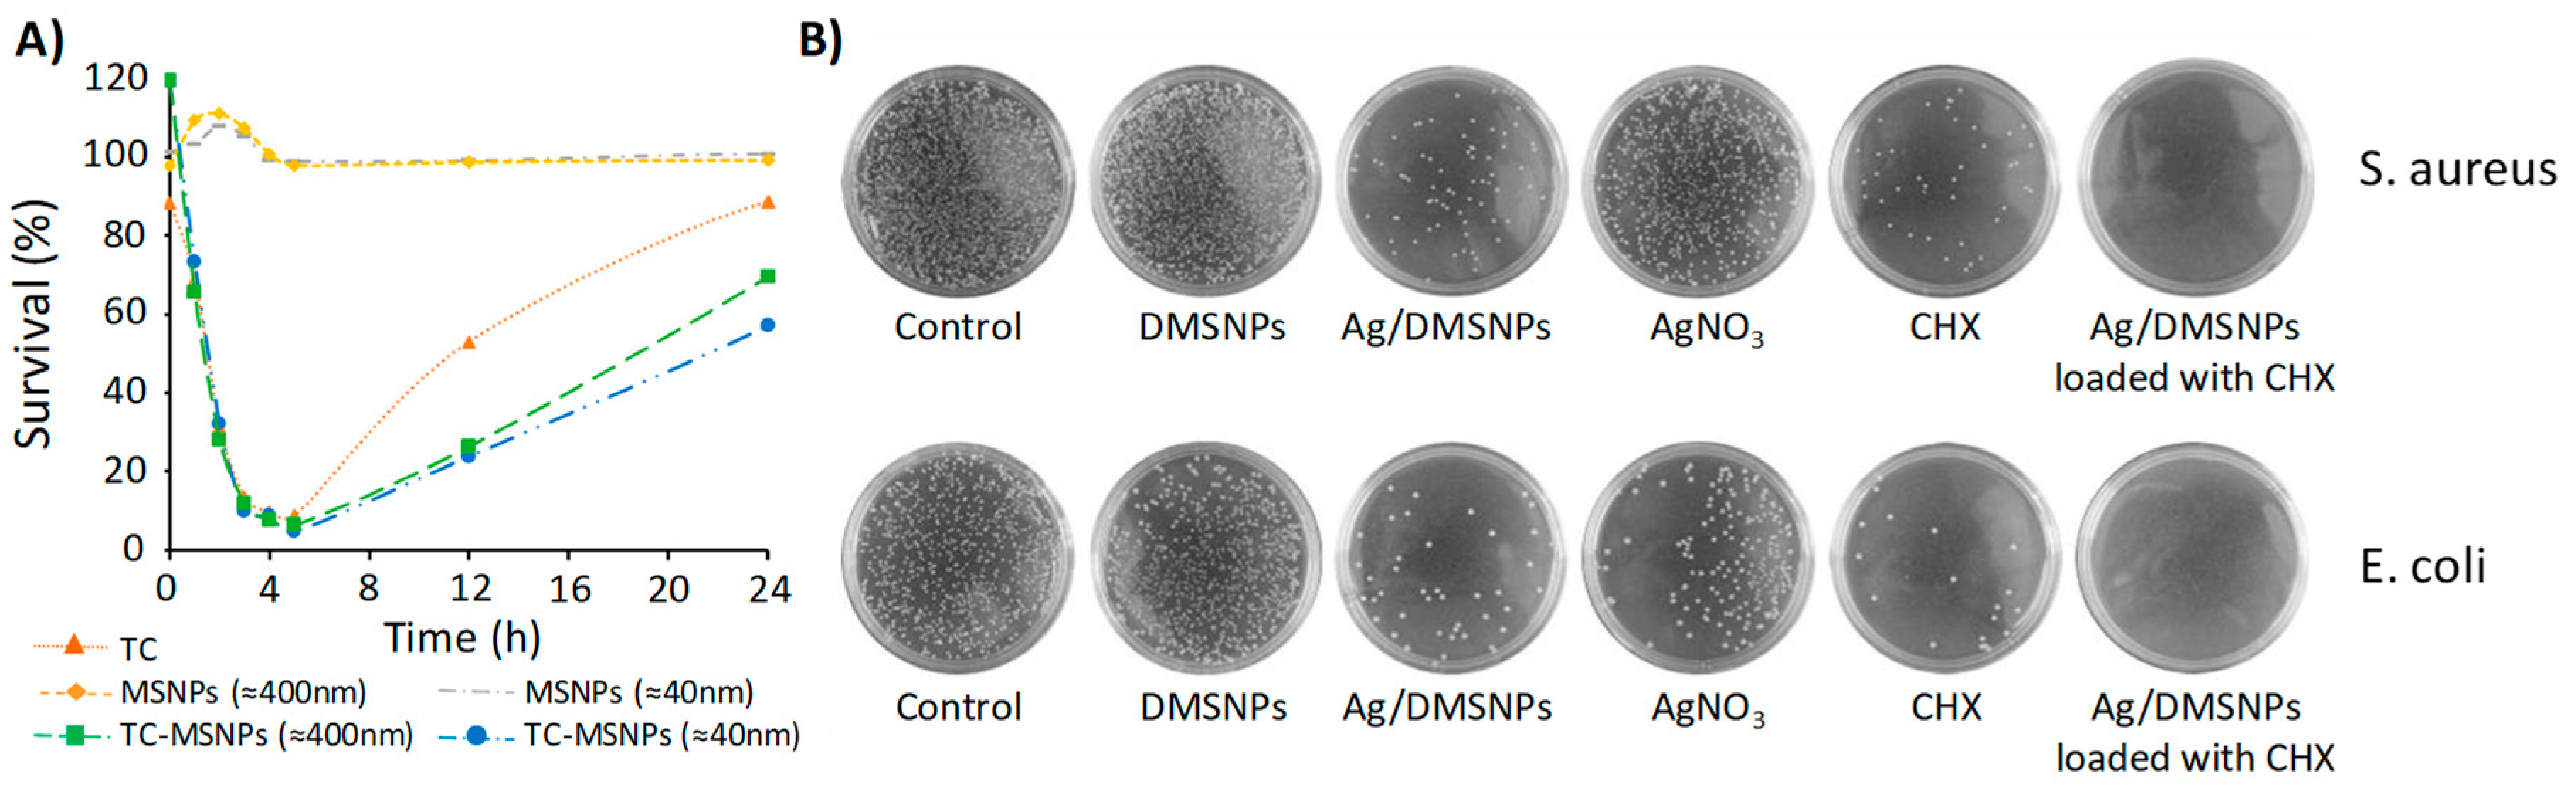

Mesoporous Silica Materials as Drug Delivery: “The Nightmare” of Bacterial Infection
Abstract
1. Introduction
1.1. Tunability of the Porous Structure
1.2. Tunability of the Shape of the Nanodevice
1.3. Tunability of the Nature of the Surface
2. Effect on Planktonic Bacteria
2.1. Targeting Bacteria
2.2. Stimulus-Responsiveness
3. Effect on Biofilms
3.1. Prevention of Biofilm Formation
3.2. Effect on the Formed Biofilms
4. Drawbacks
5. Conclusions and Future Outlook
Author Contributions
Funding
Acknowledgments
Conflicts of Interest
Abbreviations
| A. actinomycetemcomitans | Aggregatibacter actinomycetemcomitans |
| A. baumannii | Acinetobacter baumannii |
| AFM | Atomic force microscopy |
| Ag/DMSNPs | DMSNPs decorated with silver NPs |
| Ag@MSNPs | Nanoparticles with silver core and coated with mesoporous silica |
| AMSNPs-Si | (Agarose-Loaded Mesoporous Silica Nanoparticles) Coating Immobilized on Silicone Films |
| B. anthracis | Bacillus anthracis |
| B. subtilis | Bacillus subtilis |
| bth | bis(trimethoxysilyl)hexane |
| C. albicans | Candida albicans |
| CD | Cyclodextrin |
| C-dots | Carbon dots |
| Ceph | Ccphalosporin |
| CFU | Colony Forming Units |
| CIN | cinnamon |
| Cip | Ciprofloxacin |
| C-MSNPs | carboxilated MSNPs |
| DAMO | N-(2-aminoethyl)-3-aminopropyltrimethoxysilane |
| DDS | Drug delivery systems |
| DMSNPs | Dendritic mesoporous silica nanoparticles |
| DMSNPs-SB-Cu | DMSNPs supported copper |
| E. coli | Escherichia coli |
| E. faecalis | Enterococcus faecalis |
| ECDC | European Centre for Disease Prevention and Control |
| EFSA | European Food Safety Authority |
| EGCG | Epigallocatechin-3-gallate |
| EPR | Enhanced permeability and retention |
| EUC | eucalyptus |
| FB11 | Antibody for lipopolysaccharide (LPS) present in the Francisella tularensis |
| FB11-mFt LPS-MSNPs | MSNPs functionalized with an antibody for Ft LPS through a derivative of the O-antigen of Ft LPS |
| FM4-64FX | FM 4-64FX, fixable analog of FM 4-64 membrane stain |
| Fn | Francisella novocida |
| Ft LPS | lipopolysaccharide (LPS) present in F. tularensis (Ft) |
| Ft | Francisella tularensis |
| G− | Gram negative bacteria |
| G+ | Gram positive bacteria |
| G3 | polycationic dendrimer, poly(propyleneimine) dendrimer of third generation |
| Gel/SiO2-Gen NP coated Ti | titanium surface coated with a composite made of gelatin and “gentamicin-rich nuclei” silica nanoparticles |
| Gen | Gentamicin |
| HEK293 | Human embryonic kidney 293 cells |
| HKAIs | Histidine kinase autophosphorylation inhibitors |
| HMSNPs-LP | rod shaped hollow MSNPs with large cone shaped pores |
| HOMSNPs | Hollow oblate mesoporous silica nanoparticles |
| IAAH | Indole-3 Acetic Acid Complex |
| IBN-3 | Mesocellular foam |
| IBN-4 IAAH-MSNPs | Silver–Indole-3 Acetic Acid Complex based on IBN-4 silica nanoparticles |
| INH | Isoniazid |
| Izo | izohidrafural |
| K. pneumoniae | Klebsiella pneumoniae |
| Levo | Levofloxacin |
| LMU-1 bth@MSNPs | bis(trimethoxysilyl)hexane (bth) coated MSNPs with non-ordered pores |
| LMU-1 | Disordered mesoporous structure |
| LPS | Lipopolysaccharide |
| LB | Luria-Bertani liquid medium |
| lys | Lysozyme |
| M. morganii | Morganella morganii |
| M. smegmatis | Micobacterium smegmatis |
| MBI | 1-methyl-1H-benzimidazole |
| MCM-41 DAMO-MSNPs | MCM-41 type MSNPs functionalized with DAMO |
| MCM-41 G3-MSNPs | MCM-41 type MSNPs functionalized with G3 |
| MCM-41 MBI-MSNPs | 1-methyl-1H-benzimidazole functionalized MSNPs with MCM-41 structure |
| MCM-41 nHAp@MSNPs | nanohydroxyapatite/mesoporous silica nanoparticles |
| MCM-41 PMMA/MSNPs | Poly(methyl methacrylate) resine containing MCM-41 MSNPs |
| MCM-41 Van-MSNPs | MCM-41 type MSNPs functionalized with Vancomicin |
| MCM-41 ε-pLys-MSNPs | MCM-41 type MSNPs functionalized with ε-pLys |
| MCM-41 | Mesoporous structure with a hexagonal pattern |
| MCM-48 | Mesoporous structure with a cubic pattern |
| MIC | Minimun Inhibiory Concentration |
| MSM | Mesoporous silica materials |
| MSMAs/FSR film | Film made of mesoporous silica microcapsules with AgNPs supported onto the interior walls, incorporated onto the hydrophobic fluoro-silicone resin |
| MSMi | Mesoporous silica microtubes |
| MSNPs | Mesoporous silica nanoparticles, regardless of its shape |
| MSNPs@C-dots/RB | carbon dots and Rose Bengal embedded mesoporous silica nanoparticles |
| MSNPs-SB-Ni | MSNPs supported nickel |
| MSR-1/MSMi | Mesoporous silica microtubes (MSMi) with MSR-1 inside |
| MSR-1 | Magnetosopirrillum gryphiswalense |
| MXF | Moxifloxacin |
| Nafion@MSNPs | Nafion coated MSNPs |
| nHAp@MSNPs | nanohydroxyapatite/mesoporous silica nanoparticles |
| NMs | Nanomaterials |
| N-MSNPs | aminated MSNPs |
| NPs | Nanoparticles |
| ORA | orange |
| P. aeruginosa | Pseudomonas aeruginosa |
| P. mirabilis | Proteus mirabilis |
| PMMA | Poly(methyl methacrylate) |
| pMSN-GIC | Glass ionomer cement containing expanded-pore |
| PolyB | Polymyxin B |
| RB | Rose bengal |
| ROS | Reactive oxygen species |
| S. aureus | Staphylococcus aureus |
| S. enterica | Salmonella enterica |
| S. epidermidis | Staphylococcus epidermidis |
| S. mutans | Streptococcus mutans |
| S. oralis | Streptococcus oralis |
| SB | Schiff base |
| SBA-15 Ag/MSNPs | Mesoporous silica nanoparticles with hexagonal mesoporous structure and microporous connections decorated with silver NPs |
| SBA-15 DAMO-MSM | SBA15 mesoporous silica material functionalized with (N-(2-aminoethyl)-3-aminopropyltrimethoxysilane) |
| SBA-15 PMMA/MSNPs | Poly(methyl methacrylate) resine containing SBA-15 MSNPs |
| SBA-15 | Mesoporous structure with a hexagonal pattern and microporous connections |
| SEM | Scanning electron microscopy |
| Si-Ti-Sv | Silica-titania sieves |
| TC | Tetracycline |
| TEM | Transmission electron microscopy |
| Tre | Trehalose |
| Tre-HOMSNPs | Trehalose functionalized Hollow oblate mesoporous silica nanoparticles |
| UL-MSNPs | MSNPs coated with a liposome bilayer and functionalized with the ubiquicidin peptide (UBI29–41) |
| UV | Ultra violet |
| Van | Vancomicin |
| ε-pLys | ε-poly-l-lysine cationic polymer |
References
- Jeon, Y.S.; Chun, J.; Kim, B.S. Identification of household bacterial community and analysis of species shared with human microbiome. Curr. Microbiol. 2013, 67, 557–563. [Google Scholar] [CrossRef] [PubMed]
- Josephson, K.L.; Rubino, J.R.; Pepper, I.L. Characterization and quantification of bacterial pathogens and indicator organisms in household kitchens with and without the use of a disinfectant cleaner. J. Appl. Microbiol. 1997, 83, 737–750. [Google Scholar] [CrossRef] [PubMed]
- Reynolds, K.A.; Watt, P.M.; Boone, S.A.; Gerba, C.P. Occurrence of bacteria and biochemical markers on public surfaces. Int. J. Environ. Health Res. 2005, 15, 225–234. [Google Scholar] [CrossRef] [PubMed]
- Bright, K.R.; Boone, S.A.; Gerba, C.P. Occurrence of bacteria and viruses on elementary classroom surfaces and the potential role of classroom hygiene in the spread of infectious diseases. J. Sch. Nurs. 2010, 26, 33–41. [Google Scholar] [CrossRef] [PubMed]
- Sathya, A.; Vijayabharathi, R.; Gopalakrishnan, S. Plant growth-promoting actinobacteria: A new strategy for enhancing sustainable production and protection of grain legumes. 3 Biotech 2017, 7, 102. [Google Scholar] [CrossRef] [PubMed]
- Michel, V.; Martley, F.G. Streptococcus thermophilus in Cheddar cheese—Production and fate of galactose. J. Dairy Res. 2001, 68, 317–325. [Google Scholar] [CrossRef] [PubMed]
- Dodds, D.R. Antibiotic resistance: A current epilogue. Biochem. Pharmacol. 2017, 134, 139–146. [Google Scholar] [CrossRef]
- MacGowan, A.; Macnaughton, E. Antibiotic resistance. Medicine 2017, 45, 622–628. [Google Scholar] [CrossRef]
- European Food Safety Authority; European Centre for Disease Prevention and Control. The European Union summary report on antimicrobial resistance in zoonotic and indicator bacteria from humans, animals and food in 2016. EFSA J. 2018, 16, 5182. [Google Scholar] [CrossRef]
- Kumar, A.; Alam, A.; Rani, M.; Ehtesham, N.Z.; Hasnain, S.E. Biofilms: Survival and defense strategy for pathogens. Int. J. Med. Microbiol. 2017, 307, 481–489. [Google Scholar] [CrossRef] [PubMed]
- Høiby, N.; Bjarnsholt, T.; Givskov, M.; Molin, S.; Ciofu, O. Antibiotic resistance of bacterial biofilms. Int. J. Antimicrob. Agents 2018, 35, 322–332. [Google Scholar] [CrossRef] [PubMed]
- Weledji, E.P.; Weledji, E.K.; Assob, J.C.; Nsagha, D.S. Pros, cons and future of antibiotics. New Horiz. Transl. Med. 2017, 4, 9–14. [Google Scholar] [CrossRef]
- Shatzkes, K.; Connell, N.D.; Kadouri, D.E. Predatory bacteria: A new therapeutic approach for a post-antibiotic era. Future Microbiol. 2017, 12, 469–472. [Google Scholar] [CrossRef] [PubMed]
- El-Shibiny, A.; El-Sahhar, S. Bacteriophages: The possible solution to treat infections caused by pathogenic bacteria. Can. J. Microbiol. 2017, 63, 865–879. [Google Scholar] [CrossRef] [PubMed]
- Cotter, P.D.; Ross, R.P.; Hill, C. Bacteriocins—A viable alternative to antibiotics? Nat. Rev. Microbiol. 2013, 11, 95–105. [Google Scholar] [CrossRef] [PubMed]
- Naderi, A.; Kasra-Kermanshahi, R.; Gharavi, S.; Imani Fooladi, A.A.; Abdollahpour Alitappeh, M.; Saffarian, P. Study of antagonistic effects of Lactobacillus strains as probiotics on multi drug resistant (MDR) bacteria isolated from urinary tract infections (UTIs). Iran. J. Basic Med. Sci. 2014, 17, 201–208. [Google Scholar]
- Vitetta, L.; Vitetta, G.; Hall, S. Immunological Tolerance and Function: Associations Between Intestinal Bacteria, Probiotics, Prebiotics, and Phages. Front. Immunol. 2018, 9, 2240. [Google Scholar] [CrossRef]
- Eskape, G.; Drug, C.; Potential, T. Antibiotics Currently in Global Clinical Development. 2018. Available online: https://www.pewtrusts.org/en/research-and-analysis/data-visualizations/2014/antibiotics-currently-in-clinical-development (accessed on 13 December 2018).
- Zhu, X.; Radovic-Moreno, A.F.; Wu, J.; Langer, R.; Shi, J. Nanomedicine in the Management of Microbial Infection—Overview and Perspectives. Nano Today 2014, 9, 478–498. [Google Scholar] [CrossRef]
- Hemeg, H. Nanomaterials for alternative antibacterial therapy. Int. J. Nanomed. 2017, 12, 8211–8225. [Google Scholar] [CrossRef]
- Yuan, P.; Ding, X.; Yang, Y.Y.; Xu, Q.-H. Metal Nanoparticles for Diagnosis and Therapy of Bacterial Infection. Adv. Healthc. Mater. 2018, 7, 1701392. [Google Scholar] [CrossRef]
- Martínez-Carmona, M.; Gun’ko, Y.; Vallet-Regí, M. ZnO Nanostructures for Drug Delivery and Theranostic Applications. Nanomaterials 2018, 8, 268. [Google Scholar] [CrossRef] [PubMed]
- Hancock, R.E.W.; Sahl, H.-G. Antimicrobial and host-defense peptides as new anti-infective therapeutic strategies. Nat. Biotechnol. 2006, 24, 1551–1557. [Google Scholar] [CrossRef] [PubMed]
- Razei, A.; Cheraghalii, A.M.; Saadati, M.; Ramandi, M.F.; Panahi, Y. Application of nanoparticles drug delivery systems in the treatment of intracellular bacterial infections. Minerva Biotecnol. 2017, 29, 156–165. [Google Scholar] [CrossRef]
- Wang, L.; Hu, C.; Shao, L. The antimicrobial activity of nanoparticles: Present situation and prospects for the future. Int. J. Nanomed. 2017, 12, 1227–1249. [Google Scholar] [CrossRef] [PubMed]
- Eid, K.A.M.; Azzazy, H.M.E. Sustained broad-spectrum antibacterial effects of nanoliposomes loaded with silver nanoparticles. Nanomedicine 2014, 9, 1301–1310. [Google Scholar] [CrossRef] [PubMed]
- Sammour, O.A.; Hassan, H.M. Enhancement of the antibacterial activity of ampicillin by liposome encapsulation. Drug Deliv. 1996, 3, 273–278. [Google Scholar] [CrossRef]
- Cheow, W.S.; Hadinoto, K. Antibiotic Polymeric Nanoparticles for Biofilm-Associated Infection Therapy. In Microbial Biofilms: Methods and Protocols; Donelli, G., Ed.; Springer: New York, NY, USA, 2014; pp. 227–238. ISBN 978-1-4939-0467-9. [Google Scholar]
- Huang, W.; Tsui, C.P.; Tang, C.Y.; Gu, L. Effects of Compositional Tailoring on Drug Delivery Behaviours of Silica Xerogel/Polymer Core-shell Composite Nanoparticles. Sci. Rep. 2018, 8, 13002. [Google Scholar] [CrossRef]
- Vallet-Regí, M.; Manzano, M.; González-Calbet, J.M.; Okunishi, E. Evidence of drug confinement into silica mesoporous matrices by STEM spherical aberration corrected microscopy. Chem. Commun. 2010, 46, 2956–2958. [Google Scholar] [CrossRef]
- ALOthman, Z. A Review: Fundamental Aspects of Silicate Mesoporous Materials. Materials 2012, 5, 2874–2902. [Google Scholar] [CrossRef]
- Vallet-Regi, M.; Balas, F.; Arcos, D. Mesoporous materials for drug delivery. Angew. Chem. Int. Ed. 2007, 46, 7548–7558. [Google Scholar] [CrossRef]
- Hoffmann, F.; Cornelius, M.; Morell, J.; Fröba, M. Silica-Based Mesoporous Organic–Inorganic Hybrid Materials. Angew. Chem. Int. Ed. 2006, 45, 3216–3251. [Google Scholar] [CrossRef] [PubMed]
- Nishihara, H.; Kyotani, T. Templated Nanocarbons for Energy Storage. Adv. Mater. 2012, 24, 4473–4498. [Google Scholar] [CrossRef] [PubMed]
- Behrens, P.; Glaue, A.; Haggenmüller, C.; Schechner, G. Structure-directed materials syntheses: Synthesis field diagrams for the preparation of mesostructured silicas. Solid State Ion. 1997, 101–103, 255–260. [Google Scholar] [CrossRef]
- Han, Y.; Ying, J.Y. Generalized fluorocarbon-surfactant-mediated synthesis of nanoparticles with various mesoporous structures. Angew. Chem. Int. Ed. 2004, 44, 288–292. [Google Scholar] [CrossRef] [PubMed]
- Lettow, J.S.; Han, Y.J.; Schmidt-Winkel, P.; Yang, P.; Zhao, D.; Stucky, G.D.; Ying, J.Y. Hexagonal to Mesocellular Foam Phase Transition in Polymer-Templated Mesoporous Silicas. Langmuir 2000, 16, 8291–8295. [Google Scholar] [CrossRef]
- Du, X.; Qiao, S.Z. Dendritic Silica Particles with Center-Radial Pore Channels: Promising Platforms for Catalysis and Biomedical Applications. Small 2014, 11, 392–413. [Google Scholar] [CrossRef] [PubMed]
- Chen, J.-F.; Ding, H.-M.; Wang, J.-X.; Shao, L. Preparation and characterization of porous hollow silica nanoparticles for drug delivery application. Biomaterials 2004, 25, 723–727. [Google Scholar] [CrossRef]
- Kuijk, A.; Byelov, D.V.; Petukhov, A.V.; van Blaaderen, A.; Imhof, A. Phase behavior of colloidal silica rods. Faraday Discuss. 2012, 159, 181. [Google Scholar] [CrossRef]
- Hao, N.; Chen, X.; Jeon, S.; Yan, M. Carbohydrate-Conjugated Hollow Oblate Mesoporous Silica Nanoparticles as Nanoantibiotics to Target Mycobacteria. Adv. Healthc. Mater. 2015, 4, 2797–2801. [Google Scholar] [CrossRef]
- Chen, L.; Wen, Y. The role of bacterial biofilm in persistent infections and control strategies. Int. J. Oral Sci. 2011, 3, 66–73. [Google Scholar] [CrossRef]
- Hsiao, I.; Gramatke, A.M.; Joksimovic, R.; Sokolowski, M.; Gradzielski, M.; Haase, A. Size and Cell Type Dependent Uptake of Silica Nanoparticles. J. Nanomed. Nanotechnol. 2014, 5, 248. [Google Scholar] [CrossRef]
- Wehling, J.; Volkmann, E.; Grieb, T.; Rosenauer, A.; Maas, M.; Treccani, L.; Rezwan, K. A critical study: Assessment of the effect of silica particles from 15 to 500 nm on bacterial viability. Environ. Pollut. 2013, 176, 292–299. [Google Scholar] [CrossRef] [PubMed]
- Mathelié-Guinlet, M.; Béven, L.; Moroté, F.; Moynet, D.; Grauby-Heywang, C.; Gammoudi, I.; Delville, M.; Cohen-Bouhacina, T. Probing the threshold of membrane damage and cytotoxicity effects induced by silica nanoparticles in Escherichia coli bacteria. Adv. Colloid Interface Sci. 2017, 245, 81–91. [Google Scholar] [CrossRef] [PubMed]
- Slomberg, D.L.; Lu, Y.; Broadnax, A.D.; Hunter, R.A.; Carpenter, A.W.; Schoenfisch, M.H. Role of Size and Shape on Biofilm Eradication for Nitric Oxide-Releasing Silica Nanoparticles. ACS Appl. Mater. Interfaces 2013, 5, 9322–9329. [Google Scholar] [CrossRef] [PubMed]
- Vallet-Regí, M. Ordered mesoporous materials in the context of drug delivery systems and bone tissue engineering. Chemistry 2006, 12, 5934–5943. [Google Scholar] [CrossRef] [PubMed]
- Vallet-Regí, M.; Salinas, A.; Baeza, A.; Manzano, M. Smart nanomaterials and nanostructures for diagnostic and therapy. Chem. Eng. J. 2018, 340, 1–196. [Google Scholar] [CrossRef]
- Chen, L.; Zhang, J. Bioconjugated Magnetic Nanoparticles for Rapid Capture of Gram-positive Bacteria. J. Biosens. Bioelectron. 2012, 1. [Google Scholar] [CrossRef]
- Zhao, X.; Hilliard, L.R.; Mechery, S.J.; Wang, Y.; Bagwe, R.P.; Jin, S.; Tan, W. A rapid bioassay for single bacterial cell quantitation using bioconjugated nanoparticles. Proc. Natl. Acad. Sci. USA 2004, 101, 15027–15032. [Google Scholar] [CrossRef]
- Zhu, C.; Zhao, G.; Dou, W. Core-shell red silica nanoparticles based immunochromatographic assay for detection of Escherichia coli O157:H7. Anal. Chim. Acta 2018, 1038, 97–104. [Google Scholar] [CrossRef]
- Wang, R.; Xu, Y.; Jiang, Y.; Chuan, N.; Su, X.; Ji, J. Sensitive quantification and visual detection of bacteria using CdSe/ZnS@SiO2 nanoparticles as fluorescent probes. Anal. Methods 2014, 6, 6802–6808. [Google Scholar] [CrossRef]
- Gisbert-Garzarán, M.; Manzano, M.; Vallet-Regí, M. Self-immolative chemistry in nanomedicine. Chem. Eng. J. 2018, 340, 24–31. [Google Scholar] [CrossRef]
- Paris, J.L.; Mannaris, C.; Cabañas, M.V.; Carlisle, R.; Manzano, M.; Vallet-Regí, M.; Coussios, C.C. Ultrasound-mediated cavitation-enhanced extravasation of mesoporous silica nanoparticles for controlled-release drug delivery. Chem. Eng. J. 2018, 340, 2–8. [Google Scholar] [CrossRef]
- Izquierdo-Barba, I.; Colilla, M.; Vallet-Regí, M. Zwitterionic ceramics for biomedical applications. Acta Biomater. 2016, 40, 201–211. [Google Scholar] [CrossRef] [PubMed]
- Yang, S.; Han, X.; Yang, Y.; Qiao, H.; Yu, Z.; Liu, Y.; Wang, J.; Tang, T. Bacteria-Targeting Nanoparticles with Microenvironment-Responsive Antibiotic Release to Eliminate Intracellular Staphylococcus aureus and Associated Infection. ACS Appl. Mater. Interfaces 2018, 10, 14299–14311. [Google Scholar] [CrossRef] [PubMed]
- Yang, Y.; Jambhrunkar, M.; Abbaraju, P.L.; Yu, M.; Zhang, M.; Yu, C. Understanding the Effect of Surface Chemistry of Mesoporous Silica Nanorods on Their Vaccine Adjuvant Potency. Adv. Healthc. Mater. 2017, 6, 1–12. [Google Scholar] [CrossRef] [PubMed]
- Navarro-Tovar, G.; Palestino, G.; Rosales-Mendoza, S. An overview on the role of silica-based materials in vaccine development. Expert Rev. Vaccines 2016, 15, 1449–1462. [Google Scholar] [CrossRef] [PubMed]
- Vallet-Regí, M. Nanostructured mesoporous silica matrices in nanomedicine. J. Intern. Med. 2010, 267, 22–43. [Google Scholar] [CrossRef]
- Wang, Y.; Zhao, Q.; Han, N.; Bai, L.; Li, J.; Liu, J.; Che, E.; Hu, L.; Zhang, Q.; Jiang, T.; et al. Mesoporous silica nanoparticles in drug delivery and biomedical applications. Nanomed. Nanotechnol. Biol. Med. 2015, 11, 313–327. [Google Scholar] [CrossRef]
- Baeza, A.; Colilla, M.; Vallet-Regí, M. Advances in mesoporous silica nanoparticles for targeted stimuli-responsive drug delivery. Expert Opin. Drug Deliv. 2015, 12, 319–337. [Google Scholar] [CrossRef]
- Vallet-Regí, M.; Rámila, A.; del Real, R.P.; Pérez-Pariente, J. A New Property of MCM-41: Drug Delivery System. Chem. Mater. 2001, 13, 308–311. [Google Scholar] [CrossRef]
- Sevimli, F.; Yılmaz, A. Surface functionalization of SBA-15 particles for amoxicillin delivery. Microporous Mesoporous Mater. 2012, 158, 281–291. [Google Scholar] [CrossRef]
- Hashemikia, S.; Hemmatinejad, N.; Ahmadi, E.; Montazer, M. Optimization of tetracycline hydrochloride adsorption on amino modified SBA-15 using response surface methodology. J. Colloid Interface Sci. 2015, 443, 105–114. [Google Scholar] [CrossRef] [PubMed]
- Vallet-Regí, M.; Doadrio, J.C.; Doadrio, A.L.; Izquierdo-Barba, I.; Pérez Pariente, J. Hexagonal ordered mesoporous material as a matrix for the controlled release of amoxicillin. Solid State Ion. 2004, 172, 435–439. [Google Scholar] [CrossRef]
- Molina-Manso, D.; Manzano, M.; Doadrio, J.C.; Del Prado, G.; Ortiz-Pérez, A.; Vallet-Regí, M.; Gómez-Barrena, E.; Esteban, J. Usefulness of SBA-15 mesoporous ceramics as a delivery system for vancomycin, rifampicin and linezolid: A preliminary report. Int. J. Antimicrob. Agents 2012, 40, 252–256. [Google Scholar] [CrossRef] [PubMed]
- Koneru, B.; Shi, Y.; Wang, Y.; Chavala, S.; Miller, M.; Holbert, B.; Conson, M.; Ni, A.; Di Pasqua, A. Tetracycline-Containing MCM-41 Mesoporous Silica Nanoparticles for the Treatment of Escherichia coli. Molecules 2015, 20, 19690–19698. [Google Scholar] [CrossRef] [PubMed]
- Lu, M.; Wang, Q.; Chang, Z.; Wang, Z.; Zheng, X.; Shao, D.; Dong, W.; Zhou, Y. Synergistic bactericidal activity of chlorhexidine-loaded, silver-decorated mesoporous silica nanoparticles. Int. J. Nanomed. 2017, 12, 3577–3589. [Google Scholar] [CrossRef] [PubMed]
- Gounani, Z.; Asadollahi, M.A.; Meyer, R.L.; Arpanaei, A. Loading of polymyxin B onto anionic mesoporous silica nanoparticles retains antibacterial activity and enhances biocompatibility. Int. J. Pharm. 2018, 537, 148–161. [Google Scholar] [CrossRef] [PubMed]
- Balaure, P.C.; Boarca, B.; Popescu, R.C.; Savu, D.; Trusca, R.; Vasile, B.Ș.; Grumezescu, A.M.; Holban, A.M.; Bolocan, A.; Andronescu, E. Bioactive mesoporous silica nanostructures with anti-microbial and anti-biofilm properties. Int. J. Pharm. 2017, 531, 35–46. [Google Scholar] [CrossRef] [PubMed]
- Ganguly, A.; Ahmad, T.; Ganguli, A.K. Silica mesostructures: Control of pore size and surface area using a surfactant-templated hydrothermal process. Langmuir 2010, 26, 14901–14908. [Google Scholar] [CrossRef] [PubMed]
- Wang, Y.; Nor, Y.A.; Song, H.; Yang, Y.; Xu, C.; Yu, M.; Yu, C. Small-sized and large-pore dendritic mesoporous silica nanoparticles enhance antimicrobial enzyme delivery. J. Mater. Chem. B 2016, 4, 2646–2653. [Google Scholar] [CrossRef]
- Seleem, M.N.; Munusamy, P.; Ranjan, A.; Alqublan, H.; Pickrell, G.; Sriranganathan, N. Silica-antibiotic hybrid nanoparticles for targeting intracellular pathogens. Antimicrob. Agents Chemother. 2009, 53, 4270–4274. [Google Scholar] [CrossRef] [PubMed]
- Yasuyuki, M.; Kunihiro, K.; Kurissery, S.; Kanavillil, N.; Sato, Y.; Kikuchi, Y. Antibacterial properties of nine pure metals: A laboratory study using Staphylococcus aureus and Escherichia coli. Biofouling 2010, 26, 851–858. [Google Scholar] [CrossRef] [PubMed]
- Sánchez-Salcedo, S.; Shruti, S.; Salinas, A.J.; Malavasi, G.; Menabue, L.; Vallet-Regí, M. In vitro antibacterial capacity and cytocompatibility of SiO2–CaO–P2O5 meso-macroporous glass scaffolds enriched with ZnO. J. Mater. Chem. B 2014, 2, 4836–4847. [Google Scholar] [CrossRef]
- Liong, M.; France, B.; Bradley, K.A.; Zink, J.I. Antimicrobial Activity of Silver Nanocrystals Encapsulated in Mesoporous Silica Nanoparticles. Adv. Mater. 2009, 21, 1684–1689. [Google Scholar] [CrossRef]
- Carmona, D.; Lalueza, P.; Balas, F.; Arruebo, M.; Santamaría, J. Mesoporous silica loaded with peracetic acid and silver nanoparticles as a dual-effect, highly efficient bactericidal agent. Microporous Mesoporous Mater. 2012, 161, 84–90. [Google Scholar] [CrossRef]
- Tahmasbi, L.; Sedaghat, T.; Motamedi, H.; Kooti, M. Mesoporous silica nanoparticles supported copper(II) and nickel(II) Schiff base complexes: Synthesis, characterization, antibacterial activity and enzyme immobilization. J. Solid State Chem. 2018, 258, 517–525. [Google Scholar] [CrossRef]
- Al Tameemi, M.B.M.; Stan, R.; Prisacari, V.; Voicu, G.; Popa, M.; Chifiriuc, M.C.; Ott, C.; Marton, G.; Meghea, A. Antimicrobial performance of nanostructured silica–titania sieves loaded with izohidrafural against microbial strains isolated from urinary tract infections. C. R. Chim. 2017, 20, 475–483. [Google Scholar] [CrossRef]
- Liu, Y.; Liu, X.; Xiao, Y.; Chen, F.; Xiao, F. A multifunctional nanoplatform based on mesoporous silica nanoparticles for imaging-guided chemo/photodynamic synergetic therapy. RSC Adv. 2017, 7, 31133–31141. [Google Scholar] [CrossRef]
- Sun, T.; Zhang, Y.S.; Pang, B.; Hyun, D.C.; Yang, M.; Xia, Y. Engineered Nanoparticles for Drug Delivery in Cancer Therapy. Angew. Chem. Int. Ed. 2014, 53, 12320–12364. [Google Scholar] [CrossRef]
- Maeda, H. Vascular permeability in cancer and infection as related to macromolecular drug delivery, with emphasis on the EPR effect for tumor-selective drug targeting. Proc. Jpn Acad. Ser. B 2012, 88, 53–71. [Google Scholar] [CrossRef]
- Azzopardi, E.A.; Ferguson, E.L.; Thomas, D.W. The enhanced permeability retention effect: A new paradigm for drug targeting in infection. J. Antimicrob. Chemother. 2013, 68, 257–274. [Google Scholar] [CrossRef] [PubMed]
- Aparna, V.; Shiva, M.; Biswas, R.; Jayakumar, R. Biological macromolecules based targeted nanodrug delivery systems for the treatment of intracellular infections. Int. J. Biol. Macromol. 2018, 110, 2–6. [Google Scholar] [CrossRef]
- Edgar, R.; McKinstry, M.; Hwang, J.; Oppenheim, A.B.; Fekete, R.A.; Giulian, G.; Merril, C.; Nagashima, K.; Adhya, S. High-sensitivity bacterial detection using biotin-tagged phage and quantum-dot nanocomplexes. Proc. Natl. Acad. Sci. USA 2006, 103, 4841–4845. [Google Scholar] [CrossRef] [PubMed]
- Tang, E.N.; Nair, A.; Baker, D.W.; Hu, W.; Zhou, J. In Vivo Imaging of Infection Using a Bacteria-Targeting Optical Nanoprobe. J. Biomed. Nanotechnol. 2014, 10, 856–863. [Google Scholar] [CrossRef] [PubMed]
- Bandyopadhyay, A.; McCarthy, K.A.; Kelly, M.A.; Gao, J. Targeting Bacteria via Iminoboronate Chemistry of Amine-Presenting Lipids. Nat. Commun. 2015, 6, 6561. [Google Scholar] [CrossRef] [PubMed]
- Lu, H.D.; Yang, S.S.; Wilson, B.K.; McManus, S.A.; Chen, C.V.H.-H.; Prud’homme, R.K. Nanoparticle targeting of Gram-positive and Gram-negative bacteria for magnetic-based separations of bacterial pathogens. Appl. Nanosci. 2017, 7, 83–93. [Google Scholar] [CrossRef]
- Epand, R.M.; Walker, C.; Epand, R.F.; Magarvey, N.A. Molecular mechanisms of membrane targeting antibiotics. Biochim. Biophys. Acta Biomembr. 2016, 1858, 980–987. [Google Scholar] [CrossRef] [PubMed]
- Aleksandar, F.; Lu, T.K.; Vlad, A.; Yoon, C.J.; Langer, R.; Omid, C.; Link, C. Surface Charge-Switching Polymeric Nanoparticles for Bacterial Cell Wall-Targeted Delivery of Antibiotics. ACS Nano 2012, 6, 4279–4287. [Google Scholar] [CrossRef]
- González, B.; Díez, J.; Pedraza, D.; Guembe, M.; Izquierdo-barba, I.; Vallet-regí, M. Mesoporous silica nanoparticles decorated with polycationic dendrimers for infection treatment. Acta Biomater. 2018, 68, 261–271. [Google Scholar] [CrossRef]
- Ruiz-Rico, M.; Pérez-Esteve, É.; de la Torre, C.; Jiménez-Belenguer, A.I.; Quiles, A.; Marcos, M.D.; Martínez-Máñez, R.; Barat, J.M. Improving the Antimicrobial Power of Low-Effective Antimicrobial Molecules Through Nanotechnology. J. Food Sci. 2018, 83, 2140–2147. [Google Scholar] [CrossRef]
- Velikova, N.; Mas, N.; Miguel-romero, L.; Polo, L.; Stolte, E.; Zaccaria, E.; Cao, R.; Taverne, N.; Murguía, J.R.; Martinez-manez, R.; et al. Broadening the antibacterial spectrum of histidine kinase autophosphorylation inhibitors via the use of ε-poly-l-lysine capped mesoporous silica-based nanoparticles. Nanomed. Nanotechnol. Biol. Med. 2017, 13, 569–581. [Google Scholar] [CrossRef] [PubMed]
- Gustafson, H.H.; Holt-Casper, D.; Grainger, D.W.; Ghandehari, H. Nanoparticle Uptake: The Phagocyte Problem. Nano Today 2015, 10, 487–510. [Google Scholar] [CrossRef] [PubMed]
- Qi, G.; Li, L.; Yu, F.; Wang, H. Vancomycin-modified mesoporous silica nanoparticles for selective recognition and killing of pathogenic gram-positive bacteria over macrophage-like cells. ACS Appl. Mater. Interfaces 2013, 5, 10874–10881. [Google Scholar] [CrossRef] [PubMed]
- Jayawardana, K.W.; Jayawardena, H.S.N.; Wijesundera, S.A.; De Zoysa, T.; Sundhoro, M.; Yan, M. Selective targeting of Mycobacterium smegmatis with trehalose-functionalized nanoparticles. Chem. Commun. 2015, 51, 12028–12031. [Google Scholar] [CrossRef] [PubMed]
- Takayama, K.; Davidson, L.A. Antimycobacterial drugs that inhibit mycolic acid synthesis. Trends Biochem. Sci. 1979, 4, 280–282. [Google Scholar] [CrossRef]
- Thanna, S.; Sucheck, S.J. Targeting the trehalose utilization pathways of Mycobacterium tuberculosis. Medchemcomm 2016, 7, 69–85. [Google Scholar] [CrossRef] [PubMed]
- Martínez-Carmona, M.; Colilla, M.; Vallet-Regí, M. Smart Mesoporous Nanomaterials for Antitumor Therapy. Nanomaterials 2015, 5, 1906–1937. [Google Scholar] [CrossRef] [PubMed]
- Zhu, J.; Niu, Y.; Li, Y.; Gong, Y.; Shi, H.; Huo, Q.; Liu, Y.; Xu, Q. Stimuli-responsive delivery vehicles based on mesoporous silica nanoparticles: Recent advances and challenges. J. Mater. Chem. B 2017, 5, 1339–1352. [Google Scholar] [CrossRef]
- Vallet-Regí, M.; Colilla, M.; Izquierdo-Barba, I.; Manzano, M. Mesoporous Silica Nanoparticles for Drug Delivery: Current Insights. Molecules 2017, 23, 47. [Google Scholar] [CrossRef] [PubMed]
- Polo, L.; Gómez-Cerezo, N.; Aznar, E.; Vivancos, J.-L.; Sancenón, F.; Arcos, D.; Vallet-Regí, M.; Martínez-Máñez, R. Molecular gates in mesoporous bioactive glasses for the treatment of bone tumors and infection. Acta Biomater. 2017, 50, 114–126. [Google Scholar] [CrossRef] [PubMed]
- Handke, L.D.; Rogers, K.L.; Olson, M.E.; Somerville, G.A.; Jerrells, T.J.; Rupp, M.E.; Dunman, P.M.; Fey, P.D. Staphylococcus epidermidis saeR Is an Effector of Anaerobic Growth and a Mediator of Acute Inflammation. Infect. Immun. 2008, 76, 141–152. [Google Scholar] [CrossRef] [PubMed]
- Fuchs, S.; Pané-Farré, J.; Kohler, C.; Hecker, M.; Engelmann, S. Anaerobic Gene Expression in Staphylococcus aureus. J. Bacteriol. 2007, 189, 4275–4289. [Google Scholar] [CrossRef] [PubMed]
- Tamanna, T.; Bulitta, J.B.; Yu, A. Controlling antibiotic release from mesoporous silica nano drug carriers via self-assembled polyelectrolyte coating. J. Mater. Sci. Mater. Med. 2015, 26, 117. [Google Scholar] [CrossRef] [PubMed]
- Kuthati, Y.; Kankala, R.K.; Lin, S.; Weng, C.; Lee, C. pH-Triggered Controllable Release of Silver–Indole-3 Acetic Acid Complexes from Mesoporous Silica Nanoparticles (IBN-4) for Effectively Killing Malignant Bacteria. Mol. Pharm. 2015, 12, 2289–2304. [Google Scholar] [CrossRef] [PubMed]
- Jung, W.K.; Koo, H.C.; Kim, K.W.; Shin, S.; Kim, S.H.; Park, Y.H. Antibacterial Activity and Mechanism of Action of the Silver Ion in Staphylococcus aureus and Escherichia coli. Appl. Environ. Microbiol. 2008, 74, 2171–2178. [Google Scholar] [CrossRef] [PubMed]
- Dibrov, P.; Dzioba, J.; Gosink, K.K.; Häse, C.C. Chemiosmotic Mechanism of Antimicrobial Activity of Ag(+) in Vibrio cholerae. Antimicrob. Agents Chemother. 2002, 46, 2668–2670. [Google Scholar] [CrossRef]
- Park, H.-J.; Kim, J.Y.; Kim, J.; Lee, J.-H.; Hahn, J.-S.; Gu, M.B.; Yoon, J. Silver-ion-mediated reactive oxygen species generation affecting bactericidal activity. Water Res. 2009, 43, 1027–1032. [Google Scholar] [CrossRef]
- Li, Z.; Clemens, D.L.; Lee, B.Y.; Dillon, B.J.; Horwitz, M.A.; Zink, J.I. Mesoporous Silica Nanoparticles with pH-Sensitive Nanovalves for Delivery of Moxifloxacin Provide Improved Treatment of Lethal Pneumonic Tularemia. ACS Nano 2015, 9, 10778–10789. [Google Scholar] [CrossRef]
- Ruehle, B.; Clemens, D.L.; Lee, B.-Y.; Horwitz, M.A.; Zink, J.I. A Pathogen-Specific Cargo Delivery Platform Based on Mesoporous Silica Nanoparticles. J. Am. Chem. Soc. 2017, 139, 6663–6668. [Google Scholar] [CrossRef]
- Donlan, R.M. Biofilms: Microbial Life on Surfaces. Emerg. Infect. Dis. 2002, 8, 881–890. [Google Scholar] [CrossRef]
- Costerton, J.W.; Stewart, P.S.; Greenberg, E.P. Bacterial Biofilms: A Common Cause of Persistent Infections. Science 1999, 284, 1318–1322. [Google Scholar] [CrossRef] [PubMed]
- Tuson, H.H.; Weibel, D.B. Bacteria-surface interactions. Soft Matter 2013, 9, 4368–4380. [Google Scholar] [CrossRef] [PubMed]
- Lappin-Scott, H.M.; Bass, C. Biofilm formation: Attachment, growth, and detachment of microbes from surfaces. Am. J. Infect. Control 2001, 29, 250–251. [Google Scholar] [CrossRef] [PubMed]
- Pabst, B.; Pitts, B.; Lauchnor, E.; Stewart, P.S. Gel-Entrapped Staphylococcus aureus Bacteria as Models of Biofilm Infection Exhibit Growth in Dense Aggregates, Oxygen Limitation, Antibiotic Tolerance, and Heterogeneous Gene Expression. Antimicrob. Agents Chemother. 2016, 60, 6294–6301. [Google Scholar] [CrossRef] [PubMed]
- Spear, M. The Biofilm Challenge: Breaking Down the Walls. Plast. Surg. Nurs. 2011, 31, 117–120. [Google Scholar] [CrossRef] [PubMed]
- Webb, R.; Cutting, K. Biofilm the challenge. J. Wound Care 2014, 23, 519. [Google Scholar] [CrossRef] [PubMed]
- Alibert, S.; Diarra, J.N.; Hernandez, J.; Stutzmann, A.; Fouad, M.; Boyer, G.; Pagès, J.-M. Multidrug efflux pumps and their role in antibiotic and antiseptic resistance: A pharmacodynamic perspective. Expert Opin. Drug Metab. Toxicol. 2017, 13, 301–309. [Google Scholar] [CrossRef] [PubMed]
- Nicoloff, H.; Andersson, D.I. Indirect resistance to several classes of antibiotics in cocultures with resistant bacteria expressing antibiotic-modifying or -degrading enzymes. J. Antimicrob. Chemother. 2016, 71, 100–110. [Google Scholar] [CrossRef] [PubMed]
- Mooney, J.A.; Pridgen, E.M.; Manasherob, R.; Suh, G.; Blackwell, H.E.; Barron, A.E.; Bollyky, P.L.; Goodman, S.B.; Amanatullah, D.F. Periprosthetic bacterial biofilm and quorum sensing. J. Orthop. Res. 2018, 36, 2331–2339. [Google Scholar] [CrossRef] [PubMed]
- Sønderholm, M.; Bjarnsholt, T.; Alhede, M.; Kolpen, M.; Jensen, P.; Kühl, M.; Kragh, K. The Consequences of Being in an Infectious Biofilm: Microenvironmental Conditions Governing Antibiotic Tolerance. Int. J. Mol. Sci. 2017, 18, 2688. [Google Scholar] [CrossRef]
- Wolcott, R.; Dowd, S. The Role of Biofilms: Are We Hitting the Right Target? Plast. Reconstr. Surg. 2011, 127, 28S–35S. [Google Scholar] [CrossRef] [PubMed]
- Delcaru, C.; Alexandru, I.; Podgoreanu, P.; Grosu, M.; Stavropoulos, E.; Chifiriuc, M.C.; Lazar, V. Microbial Biofilms in Urinary Tract Infections and Prostatitis: Etiology, Pathogenicity, and Combating strategies. Pathogens 2016, 5, 65. [Google Scholar] [CrossRef] [PubMed]
- Soto, S.M. Importance of Biofilms in Urinary Tract Infections: New Therapeutic Approaches. Adv. Biol. 2014, 2014, 543974. [Google Scholar] [CrossRef]
- Elgharably, H.; Hussain, S.T.; Shrestha, N.K.; Blackstone, E.H.; Pettersson, G.B. Current Hypotheses in Cardiac Surgery: Biofilm in Infective Endocarditis. Semin. Thorac. Cardiovasc. Surg. 2016, 28, 56–59. [Google Scholar] [CrossRef] [PubMed]
- Boisvert, A.-A.; Cheng, M.P.; Sheppard, D.C.; Nguyen, D. Microbial Biofilms in Pulmonary and Critical Care Diseases. Ann. Am. Thorac. Soc. 2016, 13, 1615–1623. [Google Scholar] [CrossRef] [PubMed]
- Akyıldız, İ.; Take, G.; Uygur, K.; Kızıl, Y.; Aydil, U. Bacterial Biofilm Formation in the Middle-Ear Mucosa of Chronic Otitis Media Patients. Indian J. Otolaryngol. Head Neck Surg. 2013, 65, 557–561. [Google Scholar] [CrossRef] [PubMed]
- Tawfik, S.A.; Ibrahim, A.A.; Talaat, I.M.; El-Alkamy, S.S.; Youssef, A. Role of bacterial biofilm in development of middle ear effusion. Eur. Arch. Otorhinolaryngol. 2016, 273, 4003–4009. [Google Scholar] [CrossRef] [PubMed]
- Trautner, B.W.; Darouiche, R.O. Catheter-Associated Infections: Pathogenesis Affects Prevention. Arch. Intern. Med. 2004, 164, 842–850. [Google Scholar] [CrossRef] [PubMed]
- Dhir, S. Biofilm and dental implant: The microbial link. J. Indian Soc. Periodontol. 2013, 17, 5. [Google Scholar] [CrossRef] [PubMed]
- Santos, A.P.A.; Watanabe, E.; Andrade, D. de Biofilme em marca-passo artificial: Ficção ou realidade? Arq. Bras. Cardiol. 2011, 97, e113–e120. [Google Scholar] [CrossRef] [PubMed]
- Gbejuade, H.O.; Lovering, A.M.; Webb, J.C. The role of microbial biofilms in prosthetic joint infections: A review. Acta Orthop. 2015, 86, 147–158. [Google Scholar] [CrossRef] [PubMed]
- Arciola, C.R.; Campoccia, D.; Ehrlich, G.D.; Montanaro, L. Chapter 2: Biofilm-Based Implant Infections in Orthopaedics. In Biofilm-Based Healthcare-Associated Infections: Volume I; Donelli, G., Ed.; Springer International Publishing: Basel, Switzerland, 2015; pp. 29–46. ISBN 978-3-319-11037-0. [Google Scholar]
- Voo, Z.X.; Khan, M.; Xu, Q.; Narayanan, K.; Ng, B.W.J.; Bte Ahmad, R.; Hedrick, J.L.; Yang, Y.Y. Antimicrobial coatings against biofilm formation: The unexpected balance between antifouling and bactericidal behavior. Polym. Chem. 2016, 7, 656–668. [Google Scholar] [CrossRef]
- Simchi, A.; Tamjid, E.; Pishbin, F.; Boccaccini, A.R. Recent progress in inorganic and composite coatings with bactericidal capability for orthopaedic applications. Nanomedicine 2011, 7, 22–39. [Google Scholar] [CrossRef] [PubMed]
- Campoccia, D.; Montanaro, L.; Arciola, C.R. A review of the clinical implications of anti-infective biomaterials and infection-resistant surfaces. Biomaterials 2013, 34, 8018–8029. [Google Scholar] [CrossRef] [PubMed]
- Swartjes, J.J.T.M.; Sharma, P.K.; Kooten, T.G.; Mei, H.C.; Mahmoudi, M.; Busscher, H.J.; Rochford, E.T.J. Current Developments in Antimicrobial Surface Coatings for Biomedical Applications. Curr. Med. Chem. 2015, 22, 2116–2129. [Google Scholar] [CrossRef] [PubMed]
- Graham, M.V.; Mosier, A.P.; Kiehl, T.R.; Kaloyeros, A.E.; Cady, N.C. Development of antifouling surfaces to reduce bacterial attachment. Soft Matter 2013, 9, 6235–6244. [Google Scholar] [CrossRef]
- Izquierdo-Barba, I.; Sánchez-Salcedo, S.; Colilla, M.; Feito, M.J.; Ramírez-Santillán, C.; Portolés, M.T.; Vallet-Regí, M. Inhibition of bacterial adhesion on biocompatible zwitterionic SBA-15 mesoporous materials. Acta Biomater. 2011, 7, 2977–2985. [Google Scholar] [CrossRef] [PubMed]
- Martínez-Carmona, M.; Lozano, D.; Baeza, A.; Colilla, M.; Vallet-Regí, M. A novel visible light responsive nanosystem for cancer treatment. Nanoscale 2017, 9, 15967–15973. [Google Scholar] [CrossRef]
- Francolini, I.; Vuotto, C.; Piozzi, A.; Donelli, G. Antifouling and antimicrobial biomaterials: An overview. APMIS 2017, 125, 392–417. [Google Scholar] [CrossRef]
- Colilla, M.; Martínez-Carmona, M.; Sánchez-Salcedo, S.; Ruiz-Gonzales, L.; Gonzalez-Calbet, J.M.; Vallet-Regi, M. A Novel Zwitterionic Bioceramic with Dual Antibacterial Capability. J. Mater. Chem. B 2014, 2, 5639–5651. [Google Scholar] [CrossRef]
- Aguilar-Colomer, A.; Doadrio, J.C.; Pérez-Jorge, C.; Manzano, M.; Vallet-Regí, M.; Esteban, J. Antibacterial effect of antibiotic-loaded SBA-15 on biofilm formation by Staphylococcus aureus and Staphylococcus epidermidis. J. Antibiot. 2017, 70, 259–263. [Google Scholar] [CrossRef] [PubMed]
- Díez-Martínez, R.; García-Fernández, E.; Manzano, M.; Martínez, Á.; Domenech, M.; Vallet-Regí, M.; García, P. Auranofin-loaded nanoparticles as a new therapeutic tool to fight streptococcal infections. Sci. Rep. 2016, 6, 19525. [Google Scholar] [CrossRef] [PubMed]
- Cicuéndez, M.; Doadrio, J.C.; Hernández, A.; Portolés, M.T.; Izquierdo-Barba, I.; Vallet-Regí, M. Multifunctional pH sensitive 3D scaffolds for treatment and prevention of bone infection. Acta Biomater. 2018, 65, 450–461. [Google Scholar] [CrossRef] [PubMed]
- García-Alvarez, R.; Izquierdo-Barba, I.; Vallet-Regí, M. 3D scaffold with effective multidrug sequential release against bacteria biofilm. Acta Biomater. 2017, 49, 113–126. [Google Scholar] [CrossRef] [PubMed]
- Voicu, G.; Elena, A.; Andronescu, E.; Grumezescu, V.; Maria, A.; Stefan, B.; Vasile, A.; Mihai, A.; Socol, G.; Mogos, G.D.; et al. Mesoporous silica coatings for cephalosporin active release at the bone-implant interface. Appl. Surf. Sci. 2016, 374, 165–171. [Google Scholar] [CrossRef]
- Ehlert, N.; Badar, M.; Christel, A.; Lohmeier, J.; Luessenhop, T.; Stieve, M.; Lenarz, T.; Mueller, P.; Behrens, P. Mesoporous silica coatings for controlled release of the antibiotic ciprofloxacin from implants. J. Mater. Chem. 2011, 752–760. [Google Scholar] [CrossRef]
- Tamanna, T.; Landersdorfer, C.B.; Ng, H.J.; Bulitta, J.B.; Wood, P.; Yu, A. Prolonged and continuous antibacterial and anti-biofilm activities of thin films embedded with gentamicin-loaded mesoporous silica nanoparticles. Appl. Nanosci. 2018, 8, 1471–1482. [Google Scholar] [CrossRef]
- Wang, J.; Wu, G.; Liu, X.; Sun, G.; Li, D.; Wei, H. A decomposable silica-based antibacterial coating for percutaneous titanium implant. Int. J. Nanomed. 2017, 12, 371–379. [Google Scholar] [CrossRef]
- Massa, M.A.; Covarrubias, C.; Bittner, M.; Fuentevilla, I.A.; Capetillo, P.; Von Marttens, A.; Carvajal, J.C. Synthesis of new antibacterial composite coating for titanium based on highly ordered nanoporous silica and silver nanoparticles. Mater. Sci. Eng. C 2014, 45, 146–153. [Google Scholar] [CrossRef]
- Wang, W.; Liao, S.; Zhu, Y.; Liu, M.; Zhao, Q.; Fu, Y. Recent applications of nanomaterials in prosthodontics. J. Nanomater. 2015, 2015, 408643. [Google Scholar] [CrossRef]
- Shen, S.-C.; Ng, W.K.; Shi, Z.; Chia, L.; Neoh, K.G.; Tan, R.B.H. Mesoporous silica nanoparticle-functionalized poly(methyl methacrylate)-based bone cement for effective antibiotics delivery. J. Mater. Sci. Mater. Med. 2011, 22, 2283. [Google Scholar] [CrossRef] [PubMed]
- Lee, J.H.; El-Fiqi, A.; Jo, J.K.; Kim, D.A.; Kim, S.C.; Jun, S.K.; Kim, H.W.; Lee, H.H. Development of long-term antimicrobial poly(methyl methacrylate) by incorporating mesoporous silica nanocarriers. Dent. Mater. 2016, 32, 1564–1574. [Google Scholar] [CrossRef] [PubMed]
- Yu, J.; Yang, H.; Li, K.; Ren, H.; Lei, J.; Huang, C. Development of epigallocatechin-3-gallate-encapsulated nanohydroxyapatite/mesoporous silica for therapeutic management of dentin surface. ACS Appl. Mater. Interfaces 2017, 9, 25796–25807. [Google Scholar] [CrossRef] [PubMed]
- Yan, H.; Yang, H.; Li, K.; Yu, J.; Huang, C. Effects of Chlorhexidine-encapsulated mesoporous silica nanoparticles on the anti-biofilm and mechanical properties of glass ionomer cement. Molecules 2017, 22, 1225. [Google Scholar] [CrossRef]
- Banerjee, I.; Pangule, R.C.; Kane, R.S. Antifouling coatings: Recent developments in the design of surfaces that prevent fouling by proteins, bacteria, and marine organisms. Adv. Mater. 2010, 23, 690–718. [Google Scholar] [CrossRef] [PubMed]
- Zheng, J.; Li, L.; Tsao, H.-K.; Sheng, Y.-J.; Chen, S.; Jiang, S. Strong repulsive forces between protein and oligo (ethylene glycol) self-assembled monolayers: A molecular simulation study. Biophys. J. 2005, 89, 158–166. [Google Scholar] [CrossRef] [PubMed]
- Li, M.; Neoh, K.G.; Kang, E.T.; Lau, T.; Chiong, E. Surface modification of silicone with covalently immobilized and crosslinked agarose for potential application in the inhibition of infection and omental wrapping. Adv. Funct. Mater. 2014, 24, 1631–1643. [Google Scholar] [CrossRef]
- Wu, F.; Xu, T.; Zhao, G.; Meng, S.; Wan, M.; Chi, B.; Mao, C.; Shen, J. Mesoporous silica nanoparticles-encapsulated agarose and heparin as anticoagulant and resisting bacterial adhesion coating for biomedical silicone. Langmuir 2017, 33, 5245–5252. [Google Scholar] [CrossRef]
- Shao, Q.; Jiang, S. Molecular understanding and design of zwitterionic materials. Adv. Mater. 2015, 27, 15–26. [Google Scholar] [CrossRef]
- Zhang, X.; Wang, L.; Levänen, E. Superhydrophobic surfaces for the reduction of bacterial adhesion. RSC Adv. 2013, 3, 12003–12020. [Google Scholar] [CrossRef]
- Yuan, Y.; Hays, M.P.; Hardwidge, P.R.; Kim, J. Surface characteristics influencing bacterial adhesion to polymeric substrates. RSC Adv. 2017, 7, 14254–14261. [Google Scholar] [CrossRef]
- Falde, E.J.; Yohe, S.T.; Colson, Y.L.; Grinstaff, M.W. Superhydrophobic materials for biomedical applications. Biomaterials 2016, 104, 87–103. [Google Scholar] [CrossRef] [PubMed]
- Izquierdo-Barba, I.; García-Martín, J.M.; Álvarez, R.; Palmero, A.; Esteban, J.; Pérez-Jorge, C.; Arcos, D.; Vallet-Regí, M. Nanocolumnar coatings with selective behavior towards osteoblast and Staphylococcus aureus proliferation. Acta Biomater. 2015, 15, 20–28. [Google Scholar] [CrossRef] [PubMed]
- Ma, M.; Hill, R.M. Superhydrophobic surfaces. Curr. Opin. Colloid Interface Sci. 2006, 11, 193–202. [Google Scholar] [CrossRef]
- Yan, Y.Y.; Gao, N.; Barthlott, W. Mimicking natural superhydrophobic surfaces and grasping the wetting process: A review on recent progress in preparing superhydrophobic surfaces. Adv. Colloid Interface Sci. 2011, 169, 80–105. [Google Scholar] [CrossRef] [PubMed]
- Feng, L.; Li, S.; Li, Y.; Li, H.; Zhang, L.; Zhai, J.; Song, Y.; Liu, B.; Jiang, L.; Zhu, D. Super-hydrophobic surfaces: From natural to artificial. Adv. Mater. 2002, 14, 1857–1860. [Google Scholar] [CrossRef]
- Crick, C.R.; Ismail, S.; Pratten, J.; Parkin, I.P. An investigation into bacterial attachment to an elastomeric superhydrophobic surface prepared via aerosol assisted deposition. Thin Solid Films 2011, 519, 3722–3727. [Google Scholar] [CrossRef]
- Yang, H.; You, W.; Shen, Q.; Wang, X.; Sheng, J.; Cheng, D.; Cao, X.; Wub, C. Preparation of lotus-leaf-like antibacterial film based on mesoporous silica microcapsule-supported Ag nanoparticles. RSC Adv. 2014, 12, 2793–2796. [Google Scholar] [CrossRef]
- Zimmerli, W.; Moser, C. Pathogenesis and treatment concepts of orthopaedic biofilm infections. FEMS Immunol. Med. Microbiol. 2012, 65, 158–168. [Google Scholar] [CrossRef]
- Fakhro, A.; Jalalabadi, F.; Brown, R.H.; Izaddoost, S.A. Treatment of Infected cardiac implantable electronic devices. Semin. Plast. Surg. 2016, 30, 60–65. [Google Scholar] [CrossRef]
- Wu, H.; Moser, C.; Wang, H.-Z.; Høiby, N.; Song, Z.-J. Strategies for combating bacterial biofilm infections. Int. J. Oral Sci. 2014, 7, 1–7. [Google Scholar] [CrossRef] [PubMed]
- Arita-Morioka, K.I.; Yamanaka, K.; Mizunoe, Y.; Ogura, T.; Sugimoto, A.S. Novel strategy for biofilm inhibition by using small molecules targeting molecular chaperone DnaK. Antimicrob. Agents Chemother. 2015, 59, 633–641. [Google Scholar] [CrossRef] [PubMed]
- Gaidhani, S.; Singh, R.; Singh, D.; Patel, U.; Shevade, K.; Yeshvekar, R.; Ananda Chopade, B. Biofilm disruption activity of silver nanoparticles synthesized by Acinetobacter calcoaceticus PUCM 1005. Mater. Lett. 2013, 108, 324–327. [Google Scholar] [CrossRef]
- Lu, T.K.; Collins, J.J. Dispersing biofilms with engineered enzymatic bacteriophage. Proc. Natl. Acad. Sci. USA 2007, 104, 11197–11202. [Google Scholar] [CrossRef] [PubMed]
- Baker, P.; Hill, P.J.; Snarr, B.D.; Alnabelseya, N.; Pestrak, M.J.; Lee, M.J.; Jennings, L.K.; Tam, J.; Melnyk, R.A.; Parsek, M.R.; et al. Exopolysaccharide biosynthetic glycoside hydrolases can be utilized to disrupt and prevent Pseudomonas aeruginosa biofilms. Sci. Adv. 2016, 2. [Google Scholar] [CrossRef] [PubMed]
- Rukavina, Z.; Vanić, Ž. Current trends in development of liposomes for targeting bacterial biofilms. Pharmaceutics 2016, 8, 18. [Google Scholar] [CrossRef] [PubMed]
- Robinson, A.M.; Creeth, J.E.; Jones, M.N. The use of immunoliposomes for specific delivery of antimicrobial agents to oral bacteria immobilized on polystyrene. J. Biomater. Sci. Polym. Ed. 2000, 11, 1381–1393. [Google Scholar] [CrossRef] [PubMed]
- Andreozzi, E.; Barbieri, F.; Ottaviani, M.F.; Giorgi, L.; Bruscolini, F.; Manti, A.; Battistelli, M.; Sabatini, L.; Pianetti, A. Dendrimers and polyamino-phenolic ligands: Activity of new molecules against legionella pneumophila biofilms. Front. Microbiol. 2016, 7, 289. [Google Scholar] [CrossRef] [PubMed]
- Hou, S.; Zhou, C.; Liu, Z.; Young, A.W.; Shi, Z.; Ren, D.; Kallenbach, N.R. Antimicrobial dendrimer active against Escherichia coli biofilms. Bioorg. Med. Chem. Lett. 2009, 19, 5478–5481. [Google Scholar] [CrossRef] [PubMed]
- Vyas, S.; Sihorkar, V.; Dubey, P.K. Preparation, characterization and in vitro antimicrobial activity of metronidazole bearing lectinized liposomes for intra-periodontal pocket delivery. Pharmazie 2001, 56, 554–560. [Google Scholar]
- Xu, C.; He, Y.; Li, Z.; Ahmad Nor, Y.; Ye, Q. Nanoengineered hollow mesoporous silica nanoparticles for the delivery of antimicrobial proteins into biofilms. J. Mater. Chem. B 2018, 6, 1899–1902. [Google Scholar] [CrossRef]
- Pedraza, D.; Díez, J.; Izquierdo-Barba, I.; Colilla, M.; Vallet-Regí, M. Amine-functionalized mesoporous silica nanoparticles: A new nanoantibiotic for bone infection treatment. Biomed. Glas. 2018, 4, 1–12. [Google Scholar] [CrossRef]
- Stanton, M.M.; Park, B.W.; Vilela, D.; Bente, K.; Faivre, D.; Sitti, M.; Sánchez, S. Magnetotactic bacteria powered biohybrids target E. coli biofilms. ACS Nano 2017, 11, 9968–9978. [Google Scholar] [CrossRef] [PubMed]

| Type of Device a | Type of Bacteria b | Drug Loaded (w/w %) c | Ref. |
|---|---|---|---|
| MCM-41 MSNPs | E. coli | Tetracycline (17.7–18.7%) | [67] |
| MCM-41 (MSNPs, N-MSNPs, C-MSNPs) | E. coli, A. baumannii P. aeruginosa | Polymyxin B (11.3–34.7%) | [69] |
| MCM-48 MSNPs | S. aureus, E. coli, C. albicans | EUC (7%), ORA (8%), CIN (41%) essentials oils | [70] |
| DMSNPs | E. coli | Lysozyme (3.47–24.4%) | [72] |
| biodegradable silica xerogel | S. enterica | Gentamicin (31%) | [73] |
| MCM-41 Ag@MSNPs | E. coli, B. anthracis | Ag nanocrystals (-) | [76] |
| Ag/DMSNPs | S. aureus, E. coli | Chlorhexidine (10.6%) | [68] |
| SBA-15 Ag/MSNPs | S. aureus | Peracetic acid (5.3%) | [77] |
| MCM-41 (MSNPs-SB-Cu, MSNPs-SB-Ni) | E. coli, P. aeruginosa, S. aureus, B. subtilis | Gentamicin (-) | [78] |
| MCM-41 Si-Ti-Sv | E. coli, K. pneumoniae, M. morganii, P. mirabilis, E. faecalis | Izohidrafural (6.8–30%) | [79] |
| DMSNPs@C-dots/RB | E. coli | Ampicillin (18.3%) | [80] |
| Targeting Molecule a | Type of Bacteria b | Drug Loaded (w/w %) c | Type of Device d | Ref. |
|---|---|---|---|---|
| Gram negative | ||||
| G3 | E. coli | Levofloxacin (3.2–7.8%) | MCM-41 G3-MSNPs | [91] |
| ε-pLys | E. coli | HKAIs (0.5–13.8%) | MCM-41 ε-pLys-MSNPs | [93] |
| Gram positive | ||||
| Vancomicin | S. aureus | Vancomicin (anchored)(50%) | MCM-41 Van/MSNPs | [95] |
| Trehalose | M. smegmatis | INH (56.3–63.6%) | Tre-HOMSNs | [41] |
| Stimuli a | Type of Bacteria b | Drug Loaded (w/w %) c | Type of Device d | Ref. |
|---|---|---|---|---|
| pH | E. coli, B. subtilis, S. aureus, S.epidermidis | Ag+ (70%) | IBN-4 IAAH-MSNPs | [106] |
| pH | F. tularensis, F. tularensis-infected mice | Moxifloxacin (51.4%) | MCM-41 MBI-MSNPs | [110] |
| Bacterial toxins | S. aureus, S. aureus-infected mice | Gentamicin (25.6%) | MCM-41 UL-MSNPs | [56] |
| antigen Ft LPS | F. tularensis, F. novocida | Hoechst (-) | MCM-41 FB11-mFt LPS-MSNPs | [111] |
| Strategy | Type of Bacteria a | Drug Loaded (w/w %) b | Type of Device c | Ref. |
|---|---|---|---|---|
| Antimicrobial effect | S. aureus, E. coli, C. albicans | EUC (7%), ORA (8%), CIN (41%) essentials oils | MCM-48 MSNPs | [70] |
| Antimicrobial effect | S. aureus | Peracetic acid (5.3%) | SBA-15 Ag/MSNPs | [77] |
| Antimicrobial effect | S. aureus, S. epidermidis | Vancomycin (−), Rifampin (−) | SBA-15 MSNPs | [144] |
| Antimicrobial effect | E. coli | Cephalosporin (−) | MCM-48 MSNPs | [148] |
| Antimicrobial effect | P. aeruginosa | Ciprofloxacin (2 µg·cm−2) | LMU-1 bth@MSNPs | [149] |
| Antimicrobial effect | S. aureus | Gentamicin (21.9%) | MCM-41 Nafion@MSNPs | [150] |
| Antimicrobial effect | S. aureus | Gentamicin (−) | Gel/SiO2-Gen NP-coated Ti | [151] |
| Antimicrobial effect | A. actinomycetemcomitans | Ag NPs (4.26%) | AgNP/NSC-coated Ti | [152] |
| Antimicrobial effect | S. aureus | Gentamicin (−) | SBA-15 PMMA/MSNPs | [154] |
| Antimicrobial effect | C. albicans, S. oralis | Amphotericin B (2.5–7.2%) | MCM-41 PMMA/MSNPs | [155] |
| Antimicrobial effect | S. mutans | EGCG (11.29%) | MCM-41 nHAp@MSNPs | [156] |
| Antimicrobial effect | S. mutans | Chlorhexidine (44.62%) | pMCM-41-GIC | [157] |
| Anti-fouling effect | E. coli, S. aureus | Heparine (5.7%) | AMSNPs-Si | [161] |
| Anti-fouling and antimicrobial effects | S. aureus | Cephalexin (1.2%) | SBA-15 DAMO-MSM | [143] |
| Anti-fouling and antimicrobial effects | E. coli | Ag NPs (20.34%) | MSMAs/FSR film | [171] |
| Targeting Molecule a | Type of Bacteria b | Drug Loaded (w/w %) | Type of Device c | Ref. |
|---|---|---|---|---|
| - | E. coli | Lysozyme (35%) | HMSNPs-LP | [184] |
| - | S. aureus | Ag+ (70%) | IBN-4 IAAH-MSNPs | [106] |
| DAMO | E. coli, S. aureus | Levofloxacin (3.2–5.0%) | MCM-41 DAMO-MSNPs | [185] |
| G3 | E. coli | Levofloxacin (3.2–7.8%) | MCM-41 G3-MSNPs | [91] |
| MSR-1 | E. coli | Ciprofloxacin (−) | MSR-1/MSMi | [186] |
© 2018 by the authors. Licensee MDPI, Basel, Switzerland. This article is an open access article distributed under the terms and conditions of the Creative Commons Attribution (CC BY) license (http://creativecommons.org/licenses/by/4.0/).
Share and Cite
Martínez-Carmona, M.; Gun’ko, Y.K.; Vallet-Regí, M. Mesoporous Silica Materials as Drug Delivery: “The Nightmare” of Bacterial Infection. Pharmaceutics 2018, 10, 279. https://doi.org/10.3390/pharmaceutics10040279
Martínez-Carmona M, Gun’ko YK, Vallet-Regí M. Mesoporous Silica Materials as Drug Delivery: “The Nightmare” of Bacterial Infection. Pharmaceutics. 2018; 10(4):279. https://doi.org/10.3390/pharmaceutics10040279
Chicago/Turabian StyleMartínez-Carmona, Marina, Yurii K. Gun’ko, and María Vallet-Regí. 2018. "Mesoporous Silica Materials as Drug Delivery: “The Nightmare” of Bacterial Infection" Pharmaceutics 10, no. 4: 279. https://doi.org/10.3390/pharmaceutics10040279
APA StyleMartínez-Carmona, M., Gun’ko, Y. K., & Vallet-Regí, M. (2018). Mesoporous Silica Materials as Drug Delivery: “The Nightmare” of Bacterial Infection. Pharmaceutics, 10(4), 279. https://doi.org/10.3390/pharmaceutics10040279

